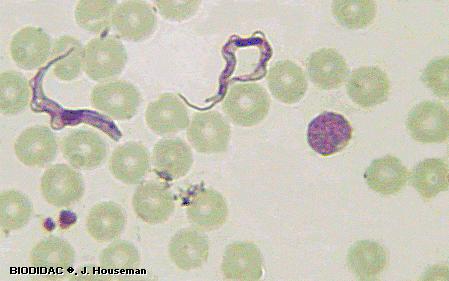
Trypanosoma entre glóbulos vermellos Trypanosoma entre glóbulos vermellos

Formato web
Tema 3: Os protistas e os fungos.
O microscopio é un instrumento imprescindible para a observación dos organismos vivos xa que todos están formados por células e estas son de tan pequeno tamaño que só así podemos velas. Este aparato ábrenos os ollos a un novo mundo, o mundo microscópico, formado por organismos unicelulares e pluricelulares moi sinxelos, e que é tan diverso coma o mundo macroscópico. Para comprobalo non temos máis que observar a través do ocular unha pequena pinga de auga estancada: bacterias (case imperceptibles), protozoos (algúns rápidos coma bólidos), algas (un mundo verde en miniatura) e outros organismos máis complexos como rotíferos (coa súa coroa rotatoria tan característica) pululan libremente. Realmente fantástico!
|
|
Ilustración 0. Alga clorofícea unicelular colonial, Volvox. BIODIDAC |
Outro instrumento moi utilizado son as lupas, que funcionan de forma semellante ao microscopio, pero para organismos algo máis grandes nos que a simple vista é difícil apreciar algunha parte ou estrutura nitidamente; permite ver, por exemplo, os esporanxios do balor do pan, un fungo moi característico que aparece no pan e outros alimentos expostos ao aire e á humidade.
|
|
Ilustración 0. Mucor sp., fungo zigomiceto con micelio branco e esporanxios negros. Found on flickrcc.net |
Tema 3: Os protistas e os fungos.
Os protozoos, características principais e exemplos.
As algas, características principais, clasificación e exemplos.
O reino Fungos: características principais, clasificación e exemplos.
Aproveitamento das algas e os fungos.
O Reino Protistas.
Engloba a todos os organismos eucariotas que non poden incluírse nos outros reinos, motivo polo cal son bastante heteroxéneos:
- Poden ser unicelulares ou pluricelulares pero nunca forman verdadeiros tecidos.
- Poden ser heterótrofos (con dixestión interna) ou autótrofos fotosintéticos ( actualmente algas unicelulares).
- Son acuáticos (de auga doce ou mariños) de vida libre pero hai algúns protozoos parasitos.
Os protozoos, características principais e exemplos.
Son organismos formados por unha única célula (unicelulares) que ten un núcleo diferenciado e moitos orgánulos (eucariotas) que lles permiten capturar alimento e dixerilo no seu interior (heterótrofos de dixestión interna); presentan os orgánulos característicos das células animais. Reprodúcense asexualmente por bipartición ou esporulación, aínda que existen especies que se reproducen sexualmente por un proceso de conxugación. Excepto algunhas especies, que son parasitas, son acuáticos de vida libre e segundo o seu mecanismo de desprazamento clasifícanse en:
|
Flaxelados |
Móvense mediante flaxelos, normalmente un ou dous. A maioría dos flaxelados teñen vida libre, pero hai algúns que son parasitos. Un famoso é o Trypanosoma gambiense. que causa a enfermidade do sono. Transmítea a mosca tse-tse, xa que o Trypanosoma vive na súa boca.
|
|
|
Ciliados |
Os ciliados desprázanse mediante multitude de cilios que son pequenas estruturas filamentosas (coma fíos) que a célula move a modo de remos. Son seres que viven libres na auga doce. Os paramecios teñen forma de sola de zapato e desprázanse activamente; as vorticelas teñen forma de copa, viven apegadas a algún material e utilizan os cilios para crear unha corrente de auga coa que atrapar alimento. |
|
|
Rizópodos |
Os rizópodos desprázanse mediante prolongacións do citoplasma, chamadas pseudópodos. Poden vivir en augas doces ou ser parasitos. As amebas son moi características pois están continuamente formando pseudópodos; a Entamoeba histolytica é un parasito intestinal que causa a amebiase en humanos. Algúns rizópodos teñen cubertas calcáreas como os foraminíferos. |
|
|
Esporozoos |
Son protozoos inmóbiles xa que carecen de apéndices locomotores. Todos os individuos deste grupo son parasitos. Un famoso é o Plasmodium falciparum, que produce a enfermidade chamada malaria ou paludismo. O Toxoplasma gondii causa a toxoplasmose.
Mosquito Anopheles que trnasmite a malaria James D. Gathany /commons.wikimedia.org |
|
As algas, características principais, clasificación e exemplos.
Son un grupo de organismos unicelulares ou pluricelulares que non chegan a formar verdadeiros tecidos (organización talofítica) todos son autótrofos fotosintéticos, é dicir, que producen o seu alimento (materia orgánica) a partir de auga, dióxido de carbono e sales minerais (materia inorgánica) utilizando a enerxía solar.
Algunhas algas complexas parécense moito a plantas pero non o son porque as súas células son todas semellante (non hai especialización) de aí que non formen tecidos nin órganos: non teñen raíces, nin talos, nin follas; tampouco teñen epiderme que impida a perda de auga o que explica que sexan todas acuáticas.
As algas reprodúcense asexualmente, por bipartición ou mediante esporas, e tamén sexualmente con formación de gametos. ![]()
A clasificación baséase principalmente na presenza de distintos pigmentos fotosintéticos que determinan o predominio dunha cor: verde, parda ou vermella.
|
Unicelulares |
Algas flaxeladas |
Móbiles con flaxelos. Parécense moito aos protozoos flaxelados pero realizan a fotosíntese. Forman parte do fitoplancto.
A euglena é abundante na auga doce. Ademais do flaxelo e a cor verde, caracterízanse pola mancha vermella, o estigma. Imaxe de Antonio Guillén; INTEF |
|
|
Diatomeas |
Caracterízanse por ter unha cuberta silícea formada por dúas partes que se axustan como unha caixa e a súa tapa. Forman parte do fitoplancto.
A cuberta silícea ou frústula pode ter formas moi variadas. Imaxe de Rubén Duro Pérez; INTEF |
|
|
|
Pluricelulares (Talo) |
Algas verdes (Clorófitas) |
Teñen esa cor debido á clorofila. Viven en augas doces e salgadas a pouca profundidade. Algunhas son unicelulares.
Durante moitos anos a principal utilidade das algas en Galicia foi a de servir como esterco. Preme aquí para velo. Imaxe de Ángel Luis Garvía Rodríguez; INTEF |
|
|
Algas pardas (Feófitas) |
Posúen un pigmento pardo amarelo moi sensible á luz polo que poden vivir a maior profundidade.
Son moi abundantes sobre as rochas como por exemplo o bocho e ás veces, coa arribazón, chegan algunhas que viven a maior profundidade como as laminarias, co aspecto dunha planta. commons.wikimedia.org |
|
|
|
Algas vermellas (Rodófitas) |
O pigmento que utilizan para facer a fotosíntese é de cor vermella. É o pigmento máis sensible á luz, polo que estas algas poden vivir a gran profundidade.
Algunhas producen unha cuberta de carbonato cálcico e xogan un papel importante na formación dos arrecifes de coral. Imaxe de Emoody26; commons.wikimedia.org |
|
O reino Fungos: características principais, clasificación e exemplos.
Son organismos eucariotas unicelulares ou pluricelulares pero que non forman tecidos nin órganos (organización talofítica), heterótrofos de dixestión externa.
Teñen células semellantes ás células animais pero con parede celular de quitina (compoñente do esqueleto de insectos), non se moven e ás veces teñen aspecto de plantas pero carecen de cloroplastos.
Viven en lugares con abundante materia orgánica, húmidos e sombríos (non precisan luz).
Reprodúcense asexualmente por xemación ou formación de esporas (xeneticamente todas iguais) ou sexualmente mediante formación de esporas (xeneticamente distintas).
Segundo a súa nutrición podemos dividilos en:
- Saprófitos; desenvólvense sobre materia orgánica morta, da cal se alimentan descompoñéndoa. Os cogomelos como o rebentabois, a cantarela, o champiñón ou a lingua de vaca son algúns exemplos.
- Parasitos; diferéncianse dos anteriores en que se desenvolven sobre materia orgánica viva, da cal se alimentan. O caruncho e o cornello (ou carnizó) son exemplos de fungos parasitos de vexetais. Na especie humana son frecuentes na pel (micose) ou as uñas (candidiase).
- Simbiontes; aliméntanse das substancias orgánicas producidas por outros seres vivos aos que lles proporciona un ambiente axeitado, beneficiándose así mutuamente. Os liques son un exemplo de simbiose entre fungos e algas. As micorrizas son producidas pola simbiose entre un fungo e as raíces dunha planta.
O corpo dos fungos está formado por un micelio, é dicir, un conxunto de filamentos formados por células máis ou menos ramificadas chamados hifas. Durante a reprodución, para formar as esporas, parte destas hifas poden agruparse e dar lugar a un corpo frutífero que denominamos cogomelo. ![]()
Segundo o tipo de esporas e hifas, os fungos clasifícanse en:
|
Nome |
Características |
Exemplo |
|
Ficomicetos ou Zigomicetos |
Son fungos simples formados por un micelio con hifas sen tabiques (células sen tabique de separación). Poden ser saprófitos coma o balor do pan ou parasitos como a mera da vide.
Imaxes de I. Rude e Marco Bressi. /commons.wikimedia.org
|
Imaxe de James_lindsey; commons.wikimedia.org |
|
Ascomicetos |
As hifas do micelio son tabicadas e as esporas fórmanse en estoxos chamados ascas ou filamentos chamados conidios. Algúns son parasitos como o Claviceps que ataca ao centeo. Outros son saprófitos como a Morchella esculenta.
Imaxe de Bernd Haynold. / commons.wikimedia.org |
commons.wikimedia.org |
|
Basidiomicetos |
Teñen hifas tabicadas e as esporas fórmanse nunha estrutura globosa denominada basidio que está no corpo frutífero ou cogomelo.
Os cogomelos poden ser comestibles pero outros son tóxicos podendo chegar a causar a morte. A Amanita muscaria é tóxica. Sabes por que lle chaman muscaria? |
Cogomelos sobre unha árbore. |
Aproveitamento das algas e os fungos.
Aínda que en occidente comezamos a usar agora as algas como alimento, en Asia (Corea, Xapón, etc.) levan milenios utilizándoas e son moi consumidas e apreciadas. Pero teñen tamén outros usos:
- Fertilizante: ata hai pouco era frecuente ver campesiños recoller algas (bocho, leituga de mar e outras) durante a baixamar para utilizar de esterco nos campos. As algas teñen un alto contido en sales minerais que ao se descompoñeren pasan ao solo enriquecéndoo destes materiais imprescindibles para as plantas.
- Na industria alimentaria: na produción de gomas (gominolas, chicles) ou como espesante (marmeladas, xeados, etc.).
- En cosmética e industria farmacéutica: polas súas propiedades hidratantes, antioxidantes e rexeneradoras de pel e cabelo son moi utilizadas en xampús, xeles de baño, cremas, etc. Tamén se utilizan dende antigo para certas enfermidades polas súas propiedades antitumorais (contra o cancro), antioxidante, redutoras de colesterol, etc.
Os fungos, en canto a usos, non se quedan atrás, e son utilizados dende a antigüidade; coa momia de Ötzi (3.300 a.C.) atopáronse restos de esca, un fungo triturado que se utilizaba para acender o lume por ser moi inflamable. Tamén se utilizan para:
- Alimentación: xa dende a época dos romanos eran apreciadas (Amanita caesare) e na actualidade existe moita afección pola súa recollida e preparación das máis diversas formas. Porén, deben ser recollidas por un especialista xa que moitas poden ser tóxicas e mesmo causaren a morte. Hai algunhas especies que se cultivan, como os champiñóns ou a pleurotus.
- Industria alimentaria: tamén se utilizan dende a antigüidade os lévedos para a fermentación na produción de viño, cervexa ou pan (Saccharomyces cerevisiae) .
- Industria farmacéutica: aínda que se utilizan outras substancias, a máis famosa pola súa contribución á medicina foi a PENICILINA, a primeira dun gran grupo de moléculas que forman parte dos medicamentos que denominamos antibióticos. Debémoslle este gran achado ao doutor Alexander Fleming, a un fungo (Penicillium notatum) e á casualidade.